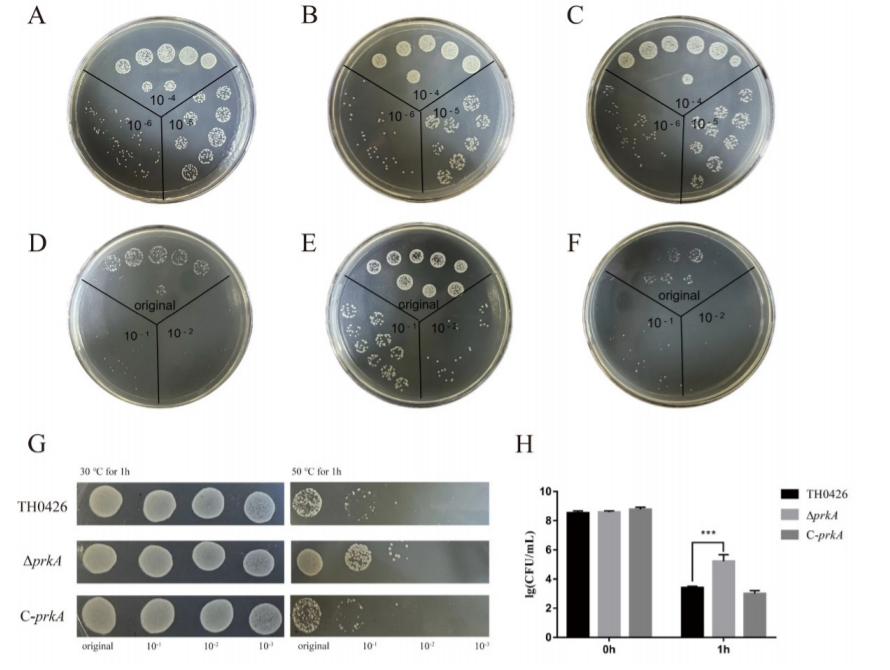

无抗生素残留的动物养殖(简称“无抗养殖”)是国家动物养殖领域发展的战略方向。近年,yl9193永利官网现代海洋牧场科学与技术团队紧扣国家需求,在海水无抗养殖方向上持续发力,近期在海水养殖生物疾病防控领域取得系列重要研究进展,相关研究成果发表于Journal of Hazardous Materials,Food Science and Human Wellness,Aquaculture,Fish & Shellfish Immunology等国际主流期刊。
进展1. 新型多药耐药大菱鲆病原菌Vibrio alfacsensis VA-1的发现
集约化海水养殖空前发展的大背景下,抗生素的不合理使用不仅加剧了环境污染,还促进了多药耐药细菌菌株的出现。团队报告并表征了从规模化大菱鲆养殖场分离的新型多重耐药弧菌病原菌Vibrio alfacsensis VA-1,并通过基因组分析解析了其致病性和多药耐药性机制。相关研究以“Unveiling the pathogenic and multidrug-resistant profiles of Vibrio alfacsensis: A potential identified threat in turbot (Scophthalmus maximus) aquaculture”为题发表于中科院一区Top期刊Journal of Hazardous Materials(IF = 12.2)上,论文第一作者为2021级博士研究生胡人阁,丛伟副教授为论文通讯作者,山东大学为唯一作者单位。

图1. 新型多药耐药大菱鲆病原菌Vibrio alfacsensisVA-1的发现
进展2. 维氏气单胞菌新毒力因子PrkA的发现及其致病机制探究
维氏气单胞菌(Aeromonas veronii)是一种广泛分布于各种水生环境和水产品中的新兴食源性病原体。团队利用体内诱导抗原技术并结合多组学技术发现了维氏气单胞菌新毒力因子PrkA,并通过基因敲除及回补技术明确了其通过Hanks型丝氨酸/苏氨酸激酶(STKs)对维氏气单胞菌毒力和温度适应性的负调控过程。相关研究以“PrkA negatively regulates the temperature tolerance and virulence of Aeromonas veronii”为题发表于中科院一区Top期刊Food Science and Human Wellness(IF = 5.6)上。论文第一作者为助理研究员康元环,李树、丛伟副教授为共同通讯作者。

图2. prkA基因缺失对维氏气单胞菌细胞毒性和斑马鱼致病性的影响
图3. prkA基因缺失对维氏气单胞菌温度适应性的影响
进展3. 抗生素天然生物替代品的相关研究
耐药性与耐药菌全球性传播使得水产养殖领域减少与限制抗生素的使用已成为广泛共识。因此,开发广谱抑菌、成本低廉且具有优异环境与生物相容性的抗生素替代品是当下的主流需求。团队通过原位筛选获得1株环境适应性好,抗菌性能及益生性能优良的凝结芽孢杆菌BC1,并通过饲喂实验进一步探讨了口服补充BC1的益生效果。此外,团队通过系统评价和荟萃分析探究了噬菌体疗法对水产养殖动物的治疗效果和影响噬菌体作用效果的潜在因素,并分析了噬菌体替代抗生素作为新型生物防治剂的可能性。相关研究分别以“Improvement of non-specific immunity, intestinal health and microbiota of crucian carp (Carassius auratus) juvenile with dietary supplementation of Bacillus coagulans BC1”和“The evaluation of bacteriophage therapy in aquaculture: A systematic review and meta-analysis”为题发表于中科院一区Top期刊Aquaculture(IF = 3.9 )。论文第一作者分别为2021级博士研究生胡人阁和2022级硕士研究生杨磊,助理研究员康元环、李树副教授及丛伟副教授为共同通讯作者。

图4.凝结芽孢杆菌BC1的筛选及鱼类肠道生理功能的改善作用

图5. 水产养殖中噬菌体疗法有效性的系统评价和荟萃分析
进展4. 抗拟态弧菌重组鱼类口服乳酸菌疫苗的研发
拟态弧菌(Vibrio mimicus)是一类严重危害水生生物健康的细菌性病原,近年来其病例报告逐年增加。团队基于拟态弧菌外膜蛋白OmpU、OmpK和霍乱毒素B亚单位(CTB)作为融合抗原,以干酪乳杆菌作为抗原口服递送系统,开发了抗拟态弧菌重组鱼类口服乳酸菌疫苗。相关研究成果申请发明专利1件(专利号:ZL202210720372.6);此外,分别以“Lc-pPG-612-OmpU-CTB: A promising oral vaccine for protecting Carassius auratus against Vibrio mimicus infection”和“Oral vaccination with recombinant Lactobacillus casei with surface displayed OmpK fused to CTB as an adjuvant against Vibrio mimicus infection in Carassius auratus”为题发表于中科院一区Top期刊Fish & Shellfish Immunology(IF = 4.1)。论文第一作者分别为实验师杨滨僮和2021级硕士研究生李洪锦,助理研究员康元环和丛伟副教授为共同通讯作者。

图6. 抗拟态弧菌感染基因工程重组口服干酪乳杆菌疫苗的构建
上述研究工作得到了国家自然科学基金、山东大学青年学者未来计划项目和山东省自然科学基金的资助。
图/文:胡人阁、丛伟 审核:杜宗军